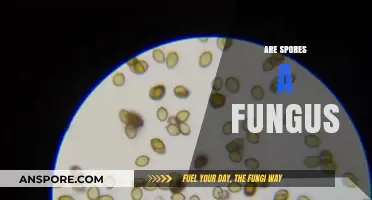
Are Spores a Fungus? Unraveling the Microscopic Mystery

In Canada, the legality of spores, particularly those related to psilocybin mushrooms, is a nuanced and evolving topic. While psilocybin itself is classified as a controlled substance under the Controlled Drugs and Substances Act (CDSA), the spores of these mushrooms, which do not contain psilocybin, occupy a legal gray area. As of now, possessing or purchasing psilocybin mushroom spores for cultivation purposes is generally considered illegal, as cultivating the mushrooms themselves is prohibited. However, spores intended for microscopy or educational purposes may not be explicitly outlawed, though their use for growing mushrooms could lead to legal consequences. The enforcement and interpretation of these laws can vary by province and jurisdiction, and recent developments, such as the decriminalization of psilocybin in some regions for medical or therapeutic use, further complicate the landscape. As such, individuals should exercise caution and stay informed about current regulations when dealing with psilocybin mushroom spores in Canada.
| Characteristics | Values |
|---|---|
| Legality of Psilocybin Mushrooms | Illegal under the Controlled Drugs and Substances Act (CDSA) |
| Legality of Psilocybin Mushroom Spores | Legal to possess, sell, and purchase for non-cultivation purposes |
| Reason for Spore Legality | Spores do not contain psilocybin or psilocin, the controlled substances |
| Exceptions for Medical Use | Limited exemptions for medical or research purposes with Health Canada approval |
| Penalties for Cultivation | Cultivation is illegal and can result in criminal charges, fines, or imprisonment |
| Recent Developments | Some cities (e.g., Vancouver) have decriminalized small amounts of psilocybin mushrooms, but federal law remains unchanged |
| Legal Status of Psilocybin | Psilocybin remains a Schedule III controlled substance under the CDSA |
| Enforcement | Law enforcement focuses on cultivation and distribution rather than spore possession |
| Public Opinion | Growing support for decriminalization and medical use of psilocybin |
| Regulatory Body | Health Canada oversees regulations and exemptions related to psilocybin and its derivatives |
Explore related products
What You'll Learn

Legal status of psilocybin spores in Canada
In Canada, the legal status of psilocybin spores is a nuanced issue that hinges on their intended use. Psilocybin, the psychoactive compound found in magic mushrooms, is classified as a Schedule III controlled substance under the *Controlled Drugs and Substances Act* (CDSA). However, psilocybin spores themselves, which do not contain the psychoactive compound, occupy a legal gray area. While possessing or cultivating mushrooms containing psilocybin is illegal without authorization, spores are often sold for microscopy or educational purposes, which is not explicitly prohibited. This distinction allows vendors to market spores as "novelty items" or "for research," avoiding direct conflict with the law.
To navigate this gray area, it’s essential to understand the intent behind spore possession. If spores are acquired for cultivation, even for personal use, it could be considered illegal under Canadian law, as growing psilocybin mushrooms would result in the production of a controlled substance. However, purchasing spores for microscopy or collection is generally tolerated, provided there is no evidence of intent to cultivate. For example, vendors often include disclaimers stating that spores are not for cultivation, shifting legal responsibility to the buyer. This loophole highlights the importance of clarity in purpose when acquiring spores.
Recent legal developments have further complicated the landscape. In 2021, Health Canada granted exemptions for end-of-life patients to use psilocybin therapy, signaling a shift in attitudes toward its medical potential. However, these exemptions do not extend to spores or cultivation for personal use. Additionally, some advocacy groups are pushing for decriminalization or legalization, citing research on psilocybin’s therapeutic benefits for conditions like depression and PTSD. While these efforts may influence future legislation, the current legal framework remains restrictive, particularly for non-medical use.
For those considering spore acquisition, practical precautions are crucial. First, research local laws and vendor reputations to ensure compliance with regulations. Second, maintain documentation that supports non-cultivation purposes, such as microscopy equipment or educational materials. Finally, stay informed about evolving legal trends, as Canada’s stance on psilocybin is subject to change. While spores themselves may not be explicitly illegal, their use and context can quickly cross legal boundaries, making informed caution the best approach.
Dandelion Puffballs: Unveiling the Truth About Their Spores and Seeds
You may want to see also

Penalties for possessing or selling spores in Canada
In Canada, the legality of possessing or selling spores hinges on their intended use, particularly whether they are linked to psilocybin mushroom cultivation. While spores themselves do not contain psilocybin, the Controlled Drugs and Substances Act (CDSA) classifies psilocybin as a Schedule III substance, making cultivation, possession, or distribution of mushrooms containing it illegal. Spores intended for cultivation of psychedelic mushrooms fall into a legal gray area, but enforcement often targets the end product rather than the spores themselves.
Penalties for possessing or selling spores with the intent to cultivate psilocybin mushrooms can be severe. Possession of spores for personal use may result in charges under Section 4 of the CDSA, carrying penalties of up to 3 years in prison and fines. However, enforcement varies by province and is often influenced by the quantity involved and the individual’s criminal history. For example, small quantities may lead to diversion programs or fines, while larger amounts could escalate to criminal charges.
Selling spores intended for psychedelic mushroom cultivation is treated more harshly. Under Section 5 of the CDSA, trafficking or distribution of substances related to Schedule III drugs can result in up to 10 years in prison for a first offense, and up to life imprisonment for subsequent offenses. Courts consider factors like profit motive, scale of operation, and prior convictions when determining sentences. Notably, vendors marketing spores for "research" or "microscopy" purposes may still face scrutiny if authorities suspect illicit intent.
Practical tips for navigating this legal landscape include avoiding explicit references to psychedelic cultivation in spore-related transactions and maintaining documentation of legitimate uses, such as educational or taxonomic study. Individuals should also be aware of provincial regulations, as some regions may have stricter enforcement policies. For instance, British Columbia and Ontario have seen higher rates of psilocybin-related arrests compared to other provinces.
In conclusion, while spores themselves are not explicitly illegal in Canada, their association with psilocybin mushroom cultivation exposes individuals to significant legal risks. Penalties range from fines and diversion programs to lengthy prison sentences, depending on intent, quantity, and prior history. Caution and awareness of both federal and provincial laws are essential for anyone handling or selling spores in Canada.
Dehumidifiers and Mold: Safe Air Solution or Spore Spreader?
You may want to see also

Differences between spore legality and mushroom legality
In Canada, the legality of spores and mushrooms diverges sharply due to their distinct roles in the lifecycle of fungi. Spores, the microscopic reproductive units of mushrooms, are generally legal to possess and sell because they do not contain psilocybin, the psychoactive compound regulated under the *Controlled Drugs and Substances Act*. This means vendors can openly market spore syringes and prints as tools for microscopy or mycological research, provided they are not advertised for cultivation or consumption. Mushrooms, however, are a different story. Fresh or dried psilocybin mushrooms are illegal to possess, cultivate, or distribute for recreational purposes, though recent exemptions for therapeutic use by healthcare professionals have created narrow legal pathways.
Consider the practical implications for enthusiasts. If you’re interested in studying fungal biology, purchasing spores is straightforward and lawful. For instance, a hobbyist in Ontario could legally acquire a spore syringe to examine under a microscope, as long as they avoid germinating the spores into mycelium. Conversely, attempting to grow mushrooms from those spores would violate federal law, as the resulting fruiting bodies would contain psilocybin. This distinction highlights the importance of intent: spores are regulated based on their use, while mushrooms are inherently controlled due to their chemical composition.
From a legal standpoint, the enforcement of these laws varies. Law enforcement typically targets mushroom cultivation or distribution rather than spore possession, as spores themselves are inert and lack psychoactive properties. However, courts have prosecuted individuals who cultivate mushrooms, even if they claim the spores were intended for research. For example, a 2021 case in British Columbia saw a grower fined for producing psilocybin mushrooms, despite arguing their initial purpose was scientific study. This underscores the need for clarity in both intent and action when handling fungal materials.
For those navigating this landscape, here’s a practical tip: always document your purpose if you’re working with spores. Label containers as “for microscopy only” and avoid any equipment associated with cultivation, such as grow tents or substrates. While this won’t guarantee immunity from scrutiny, it demonstrates compliance with the spirit of the law. Conversely, if you’re exploring therapeutic use of mushrooms, consult a healthcare provider to understand the legal exemptions under Health Canada’s Special Access Program or recent regulatory changes.
In summary, the legality of spores and mushrooms in Canada hinges on their biological function and chemical content. Spores remain largely unregulated due to their non-psychoactive nature, while mushrooms face strict controls. By understanding this distinction and adhering to legal boundaries, individuals can engage in mycological pursuits without risking penalties. Whether for research, education, or therapy, clarity and caution are key in this evolving legal landscape.
Psilocybin Spores in Puerto Rico: Legal Status Explained
You may want to see also
Explore related products

Provincial variations in spore regulations across Canada
Canada's stance on spore legality is nuanced, with provincial regulations often diverging from federal guidelines. While spores themselves are not explicitly illegal under federal law, their cultivation and use for psychoactive purposes fall into a legal gray area. This ambiguity creates a patchwork of provincial regulations that can be confusing for individuals and businesses alike.
Understanding the Provincial Landscape
British Columbia stands out as a province with a relatively progressive approach. While psilocybin mushrooms remain illegal, possession of small amounts for personal use is often treated as a low-priority offense by law enforcement. This de facto tolerance has fostered a growing community of enthusiasts and researchers exploring the therapeutic potential of psychedelics. In contrast, Quebec takes a stricter stance, with possession of any amount of psilocybin mushrooms carrying potential criminal penalties. This disparity highlights the importance of understanding local laws before engaging with spores or related substances.
Alberta presents an interesting case study. While spores themselves are not explicitly prohibited, the province has taken steps to restrict access to grow kits and other cultivation materials. This indirect approach aims to curb the production of psychoactive mushrooms without directly criminalizing spore possession.
Navigating the Gray Area: Practical Considerations
For those interested in spore-related activities, understanding provincial nuances is crucial. Ontario, for example, allows the sale of spores for microscopy and taxonomic purposes, but cultivation for psychoactive use remains illegal. This distinction requires careful consideration of intent and potential consequences. Individuals should research local regulations thoroughly and consult legal professionals if unsure.
Saskatchewan illustrates the potential for rapid regulatory change. Recent discussions within the province suggest a possible shift towards decriminalization of psilocybin mushrooms for therapeutic use. This highlights the dynamic nature of spore regulations and the need for ongoing awareness.
Looking Ahead: A Call for Harmonization
The lack of uniform spore regulations across Canada creates challenges for individuals, researchers, and businesses. A more cohesive national framework, informed by scientific evidence and public health considerations, would provide clarity and consistency. Until then, individuals must navigate the provincial patchwork with caution, prioritizing legal compliance and responsible practices.
Are Moss Spores Poisonous? Uncovering the Truth About Moss Safety
You may want to see also

Loopholes in Canadian law regarding spore cultivation
In Canada, the legality of spores hinges on their intended use, creating a gray area that cultivators often navigate. Under the Controlled Drugs and Substances Act (CDSA), psilocybin—the psychoactive compound in magic mushrooms—is illegal. However, spores themselves, which do not contain psilocybin, are not explicitly prohibited. This distinction allows for the sale and possession of spores for non-cultivation purposes, such as microscopy or collection. Yet, the moment spores are used to grow mushrooms, the activity becomes illegal. This loophole permits vendors to sell spores openly, often with disclaimers emphasizing their "novelty" or "educational" value, while buyers must tread carefully to avoid crossing legal boundaries.
One practical loophole lies in the enforcement of the law rather than its wording. While cultivating psilocybin mushrooms is illegal, law enforcement rarely targets individuals possessing spores unless there is clear evidence of cultivation. This creates a de facto tolerance for spore possession, especially in small quantities. For instance, hobbyists often purchase spore syringes or prints from online vendors without facing legal repercussions, provided they do not grow mushrooms. However, this leniency is not a guarantee; high-profile cases or large-scale operations can attract scrutiny. Cultivators must remain vigilant, as the line between legal possession and illegal activity is thin and subjective.
Another loophole emerges from the lack of specificity in Canadian legislation regarding spore viability. Spores sold for microscopy are often marketed as "not guaranteed to be viable," which technically complies with the law. However, many vendors quietly ensure their products are viable, knowing buyers intend to cultivate them. This unspoken understanding allows the market to thrive while maintaining a veneer of legality. For those interested in cultivation, selecting reputable vendors who provide high-quality, viable spores is crucial, though this practice remains legally risky.
Comparatively, Canada’s approach differs from countries like the Netherlands, where spore cultivation is tolerated under certain conditions. In Canada, the focus remains on psilocybin rather than spores, leaving room for interpretation. Advocates argue that decriminalizing spore cultivation could reduce harm by allowing controlled, small-scale growth for personal use. Until such changes occur, individuals must rely on these loopholes, balancing their interests with legal caution. Practical tips include keeping spore collections discreet, avoiding public discussion of cultivation intentions, and staying informed about evolving regulations.
Are Spore-Grown Plants Harmful? Unveiling the Truth About Their Safety
You may want to see also
Frequently asked questions
Spores themselves are not illegal to possess in Canada. However, cultivating mushrooms from spores for psychoactive purposes (e.g., psilocybin-containing mushrooms) is illegal under the *Controlled Drugs and Substances Act*.
Yes, purchasing spores for microscopy, research, or educational purposes is legal in Canada. However, using them to grow psychoactive mushrooms is prohibited.
As of 2023, there are limited exceptions for medical use of psilocybin under Health Canada’s Special Access Program. Otherwise, spores remain legal only for non-cultivation purposes.